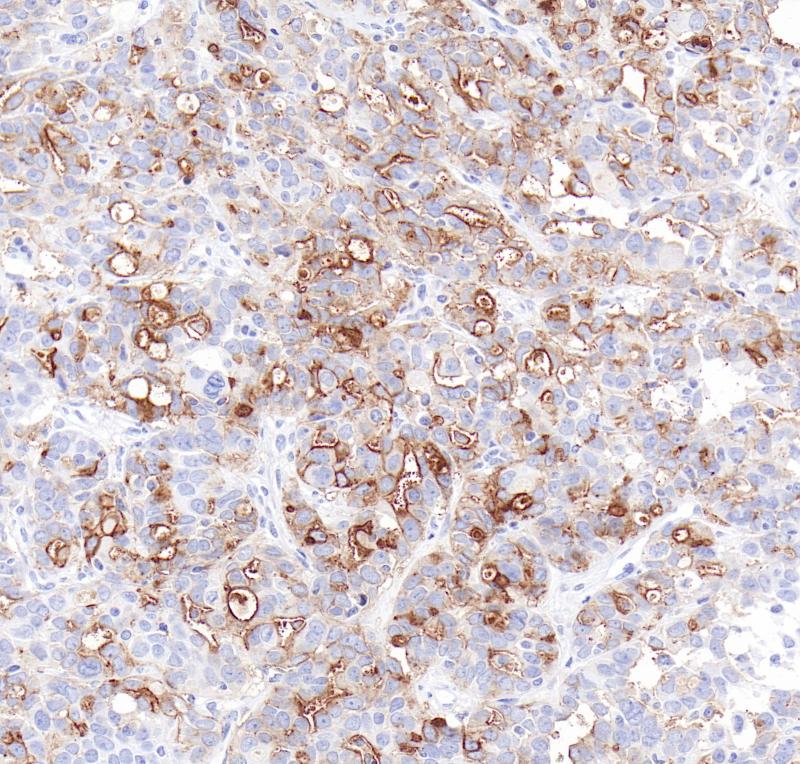
卵巢癌FRα（BP6286）染色

产品中心
卵巢癌FRα(BP6286)染色
FRα 重组兔单克隆抗体
叶酸受体α (FRα)是一种糖基磷脂酰肌醇连接的细胞表面糖蛋白,在中性PH下对叶酸和叶酸类似物具有高亲和力。它是叶酸受体家族的成员,该家族包括FRα、FRβ(72%同源性)、FRγ(68%同源性)。大多数正常组织几乎不表达FRα,在卵巢癌、三阴性乳腺癌、子宫内膜腺癌和非小细胞肺癌(NSCLC)中表达水平较高。研究表明FRα可促进肿瘤生长与患者的预后相关,使之成为一个很好的抗肿瘤药物开发靶点。
Specifications
- 目录号
- BX50309
- 克隆号
- BP6286
- 阳性对照
- 卵巢癌
- 亚细胞定位
- 细胞膜,细胞质
- 组织类型
- FFPE
- 修复方式
- HIER
- 稀释比
- 1:100-1:200
- 规格
- 100μl/vial, 1ml/vial
- 用途
- RUO
Reference
1. Ab O, Whiteman KR, et al. Mol Cancer Ther.14(7):1605-13, 2015 Jul.
2. Della-Longa S, Arcovito A. J Mol Graph Model. 44:197-207, 2013 Jul.


